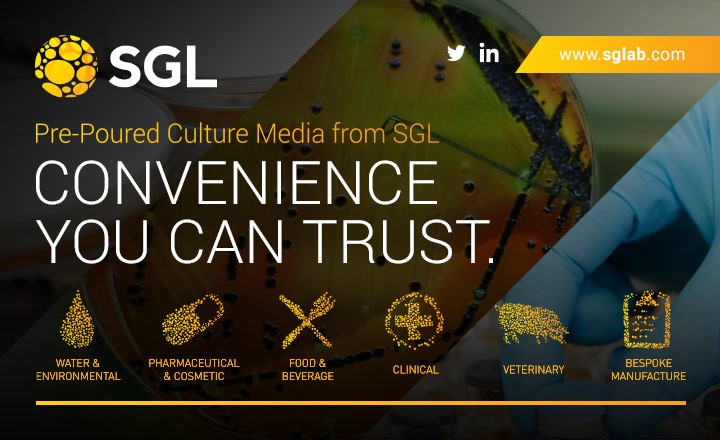
SGL Prepared Media

A new year is the ideal moment for microbiology laboratories to take a fresh look at one of the most important inputs in the workflow: culture media. If your lab is under pressure to improve turnaround, strengthen compliance, or reduce waste, your media supplier is a great place to start.
SGL (Southern Group Laboratory) is an independent UK manufacturer of prepared culture media and associated microbiology products, supporting laboratories across Clinical & Veterinary, Food & Beverage, Pharmaceutical & Cosmetic, and Water & Environmental testing. Our focus is simple: convenience you can trust.
When you review your exisiting supplier or in house manufacture, look beyond a unit price.
1) Cost – compare on cost-per-result
The true cost of culture media includes more than the invoice. Remakes, failures, short shelf life, storage, and internal labour quickly outweigh small differences in price-per-plate or bottle. If you want a clear benchmark, SGL offers a cost comparison quote—share your current product details (including formulation, format and fill volume) and we’ll provide a like-for-like quotation.
2) Quality – choose media you can defend in an audit
Consistency matters. SGL products are manufactured under an ISO 9001 quality system, with representative samples quality controlled in our UKAS-accredited ISO/IEC 17025 laboratory. QC test methods are based on ISO 11133, with rigorous release criteria designed to confirm each batch is fit for purpose.
3) Documentation & validation support – make evidence easy
When an auditor asks (or you need to investigate a trend), the right documentation and technical support should be readily available. SGL provides online access to Certificates of Analysis via a batch number search, supported by a full Technical Data Sheet and Material Safety Data Sheet library. In addition, our technical team supports customer validation activities, helping laboratories with media change assessments, method transfer, and validation planning when introducing new or alternative culture media.
4) Flexibility – fit your process, not the other way round
Alongside standard products, SGL supports bespoke and proprietary formulations, with the ability to tailor formulation, format, fill size, packaging and even QC testing to suit your workflow. This applies to both pre-poured plate media and bottled media, allowing laboratories to specify plate formats, bottle volumes, closures, diluents or enrichment formats, and order small batch sizes with short lead times as demand changes.
5) Formats & packaging – ready for routine and critical environments
SGL’s pre-poured plates are available in multiple formats including 55mm, 90mm and 140mm, plus square plates, bi-plates and contact plates. Plates can be aseptically filled or gamma irradiated, with packaging tailored from single wrap through to triple-wrapped VHP-impermeable options for critical environments. Bottled media can likewise be supplied in formats aligned to routine testing, validation or specialist applications.
If any part of your current culture media supply feels rigid, hard to evidence, or more expensive than it should be, make a supplier review your first quality improvement step of the year—and benchmark against SGL.